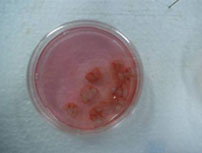

威斯腾生物经过10多年的发展,获得了上百种细胞株和四十余钟原代细胞培养经验,并建立了庞大的细胞库及原代培养资料库;细胞平台有资深实验员、规范的SOP操作文件,万级净化细胞房,这些条件为保质保量完成每个客户的实验提供了保障。同时,威斯腾生物结合多年原代及传代细胞培养经验,结合平台已有的技术优势,建立了完善的体外药筛实验,并引进RTCA(Real-time cellular Analysis,实时无标记细胞记录仪),在药筛过程中,全程实时记录细胞真实状况,为药筛提供最真实精准的实验数据。威斯腾生物与上海中科院生物与细胞所化学生物学技术平台合作,享有英国国家医学研究院科技转化部MRCT独家提供的约1万种核心结构小分子化合物库资源,基于成药性结构设计,特别适于进行以新药研发为目的的活性化合物筛选。精选SiRNA库,包含20个亚库,可根据需求定制提高通路筛选。
原代细胞培养案例
1. 大鼠大脑皮质神经细胞的原代培养
实验步骤如下:
 |
 |
 |
|
| 新生鼠 |
酒精浸泡 |
剥离脑组织 |
大脑皮质 |
 |
 |
 |
 |
| 剥离血管 |
洗涤 |
剪碎消化 |
200目不锈钢网过滤 |
细胞鉴定:
2. 骨髓间充质干细胞BMSCs的原代培养
实验步骤如下
 |
 |
 |
 |
| SD乳大鼠颈椎脱臼法处死 |
分离出大鼠股骨和胫骨 |
分离出大鼠股骨和胫骨 |
剔除骨头表面肌肉 |
细胞鉴定:
中心可提供的原代培养种类:
| 原代细胞名称 |
来源 |
分离时间 |
鉴定指标 |
鉴定方法 |
| 大鼠脑星形胶质细胞 |
大鼠 |
3-4h |
胶质纤维酸性蛋白(GFAP) |
IHC/IF |
| 大鼠皮层神经元细胞 |
大鼠 |
3-4h |
神经元特异性烯醇化酶(NSE) |
IHC/IF |
| 骨髓间充质干细胞 |
大鼠/小鼠/兔 |
3-4h |
CD44+CD34- |
流式表面抗原检测 |
| 小鼠小胶质细胞 |
小鼠 |
3-4h |
Iba1 |
IHC/IF |
| 大鼠血管内皮细胞 |
大鼠 |
3-4h |
Ⅷ因子相关抗原 |
IHC/IF |
| 大鼠膀胱逼尿肌细胞 |
大鼠 |
3-4h |
α-SM-Actin |
IHC/IF |
| 大鼠心肌细胞 |
大鼠 |
4-5h |
α-actin |
IHC/IF |
| 大鼠心肌成纤维细胞 |
大鼠 |
3-4h |
a-SA抗体 |
IHC/IF |
| 小鼠血管平滑肌细胞 |
小鼠 |
3-4h |
肌动蛋白α-SMA |
IHC/IF |
| 大鼠牙源性间充质细胞 |
大鼠 |
3-4h |
波形丝蛋白(vimentin)
角蛋白(keratin) |
IHC/IF |
| 小鼠脾脏淋巴细胞 |
小鼠 |
|
|
|
| 小鼠巨噬细胞 |
小鼠 |
|
|
|
| 小鼠附睾精子细胞 |
小鼠 |
|
|
|
| 老年鼠脂肪间充质干细胞 |
老年鼠 |
3-4h |
D44+CD45- |
流式表面抗原检测 |
| 瘢痕组织成纤维细胞 |
瘢痕组织 |
3-4h |
波形蛋白 |
IHC/IF |
| 大鼠皮层神经元干细胞﹡ |
大鼠 |
3-4h |
Nestin |
IHC/IF |
| 骨髓源性内皮祖细胞(EPCs)﹡﹡ |
骨髓 |
3-4h |
CD34与CD133 |
IHC/IF |
﹡:神经元干细胞原代培养通常需要额外的细胞因子如B-27、EGF、bFGF
﹡﹡:EPCs原代培养需要特殊培养基
细胞平台展示:
 |
 |
 |
| 万级净化细胞房 |
超净工作台 |
荧光显微镜 |
 |
 |
 |
| RTCA仪器 |
RTCA实现多功能实时无标记检测 |
RTCA筛选特定作用机制的抗肿瘤药物 |
 |
 |
 |
| 高内涵细胞分析仪Opera |
高通量自动化药物筛选实验平台 |
高通量自动化siRNA文库实验平台 |
|
|
| 细胞生物学检测 |
|
| 原代细胞培养 |
|
| CRISPR/Cas9细胞敲除/敲入 |
|
| 联系我们 |
|
|
